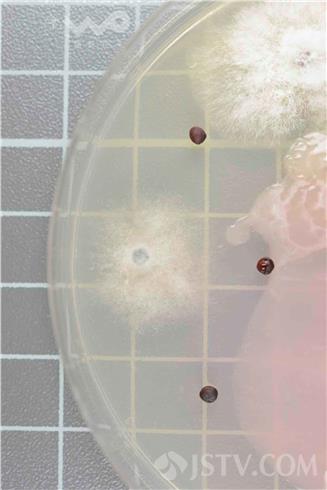

11月4日,镇江检验检疫局宣布,该局检验检疫人员在对一艘来自法国的40500吨大麦实施表层检验检疫时,发现大麦中夹带有油菜籽。检疫人员随即对油菜籽进行了送样检测,并最终从中检测出油菜茎基溃疡病菌,这是镇江口岸再次截获该病菌。
“这批大麦从法国来,而法国属于油菜茎基溃疡病疫区,所以发现夹带的油菜籽之后,我们十分谨慎,立刻将油菜籽送样至江苏检验检疫局动植食中心,做针对性茎基溃疡病检测。”镇江检验检疫局检验检疫人员介绍说,“大麦中夹带油菜籽并最终检测出该病菌的案例很多,今年江苏口岸就发生了两次,4月江阴口岸从来自加拿大大麦夹带的油菜籽中截获了该病菌,6月连云港口岸对来自澳大利亚大麦夹带的油菜籽中也均截获过该病菌,全国其他口岸如舟山口岸曾经也发生过。”
据介绍,油菜茎基溃疡病菌是一种引起油菜茎基部发病的强致病力真菌,它引起的油菜茎溃疡病是油菜主要致病之一,能导致整个植株的坏死。除此之外,该病菌还可导致白菜、甘蓝、芥蓝等30余种十字花科植物茎基溃疡、倒伏和死亡,在北美、法国、澳大利亚等地区分布广泛,每年在世界范围内能造成约9亿美元的损失。中国目前尚无该病菌的分布报道,该病害一旦传入,将严重危害我国油菜等产业。
镇江检验检疫局及时要求进口企业将卸下的大麦定点堆放、定点加工,并对卸货和发运过程中下脚料、残渣等进行严格的销毁处理;对卸货、储存和发运全过程进行监管,并做好相关记录;同时联系指运地湖南、江西和重庆检验检疫局,协同做好该批大麦的后续监管工作,严格防范疫情逃逸扩散。

我要说两句